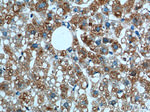
MGAT1 Antibody in Immunohistochemistry (Paraffin) (IHC (P))

Search
Proteintech
MGAT1 Polyclonal Antibody
{{$productOrderCtrl.translations['antibody.pdp.commerceCard.promotion.promotions']}}
{{$productOrderCtrl.translations['antibody.pdp.commerceCard.promotion.viewpromo']}}
{{$productOrderCtrl.translations['antibody.pdp.commerceCard.promotion.promocode']}}: {{promo.promoCode}} {{promo.promoTitle}} {{promo.promoDescription}}. {{$productOrderCtrl.translations['antibody.pdp.commerceCard.promotion.learnmore']}}
产品信息
15103-1-AP
种属反应
已发表种属
宿主/亚型
分类
类型
抗原
偶联物
形式
浓度
规格
纯化类型
保存液
内含物
保存条件
运输条件
产品详细信息
Immunogen sequence: VIPILVIAC DRSTVRRCLD KLLHYRPSAE LFPIIVSQDC GHEETAQAIA SYGSAVTHIR QPDLSSIAVP PDHRKFQGYY KIARHYRWAL GQVFRQFRFP AAVVVEDDLE VAPDFFEYFR ATYPLLKADP SLWCVSAWND NGKEQMVDAS RPELLYRTDF FPGLGWLLLA ELWAELEPKW PKAFWDDWMR RPEQRQGRAC IRPEISRTMT FGRKGVSHGQ FFDQHLKFIK LNQQFVHFTQ LDLSYLQREA YDRDFLARVY GAPQLQVEKV RTNDRKELGE VRVQYTGRDS FKAFAKALGV MDDLKSGVPR AGYRGIVTFQ FRGRRVHLAP PPTWEGYDPS WN (105-445 aa encoded by BC003575)
靶标信息
There are believed to be over 100 different glycosyltransferases involved in the synthesis of protein-bound and lipid-bound oligosaccharides. UDP-N-acetylglucosamine:alpha-3-D-mannoside beta-1, 2-N-acetylglucosaminyltransferase I is a medial-Golgi enzyme essential for the synthesis of hybrid and complex N-glycans. The protein, encoded by a single exon, shows typical features of a type II transmembrane protein. The protein is believed to be essential for normal embryogenesis. Several variants encoding the same protein have been found for this gene.
仅用于科研。不用于诊断过程。未经明确授权不得转售。
生物信息学
蛋白别名: Alpha-1,3-mannosyl-glycoprotein 2-beta-N-acetylglucosaminyltransferase; glcNAc-T I; GNT-I; mannoside acetylglucosaminyltransferase 1; mannosyl (alpha-1,3-)-glycoprotein beta-1,2-N-acetylglucosaminyltransferase; MGAT1; MGAT1 gene for N-acetylglucosaminyltransferase; N-acetylglucosaminyltransferase I; N-glycosyl-oligosaccharide-glycoprotein N-acetylglucosaminyltransferase I; OTTHUMP00000161546; unnamed protein product
基因别名: GGNT1; GLCNAC-TI; GLCT1; GLYT1; GNT-1; GNT-I; Gnt1; GnTI; MGAT; Mgat-1; MGAT1
UniProt ID: (Human) P26572, (Rat) Q09325, (Mouse) P27808
Entrez Gene ID: (Human) 4245, (Rat) 81519, (Mouse) 17308